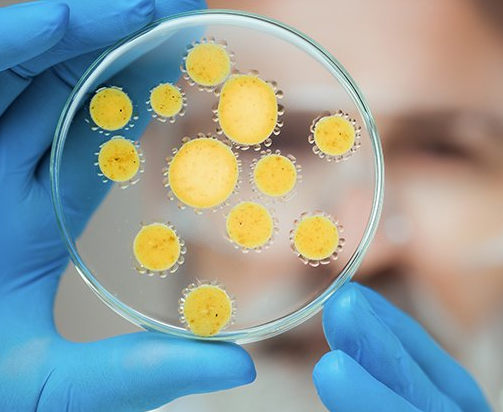
DOCÊNCIA EM CONTABILIDADE PÚBLICA

Descrição
Taxa de matrícula: R$ 300,00
Cupom: Use o cupom “MATRICULAZERO” e fique isento da taxa)*
Material: Online Gratuito
DOCÊNCIA EM CONTABILIDADE PÚBLICA
Objetivos
O Curso de Pós-graduação em Docência em Contabilidade Pública, tem como objetivo ampliar a compreensão de concepções acerca da Contabilidade Pública e refletir sobre as respectivas implicações para o exercício da docência no Ensino Superior. Favorecer a formação crítica e criativa do aluno pós-graduando, destacando seu papel profissional como docente em Contabilidade Pública; Desenvolver atividades de pesquisa, na área de Contabilidade Pública, apresentando autonomia intelectual e espírito investigativo; Exercitar normas científicas na elaboração de trabalhos acadêmicos tais como: projeto de pesquisa, artigo acadêmico, monografia, entre outros.
Público Alvo
O Curso de Pós-graduação em Docência em Contabilidade Pública, destina-se a profissionais de nível superior em contabilidade, administração de empresas, economia, servidores públicos nas esferas federais, estaduais e municipais, dos poderes executivo, legislativo e judiciário e do Ministério Público e candidatos à carreira na administração pública.
Carga Horária
N° | Disciplinas | Ch |
01 | Ética Geral E Profissional | 40 h |
02 | Metodologia Científica | 40 h |
03 | Direitos Humanos | 40 h |
04 05 06 07 08 09 10 11 12 13 14
| Língua Brasileira de Sinais – Libras Docência do Ensino Superior Inovações Tecnológicas Gestão Pública Controladoria e Auditoria Contabilidade Fiscal e Tributária Planejamento e Orçamento Público e Gestão Orçamentária Licitação Pública Contabilidade Pública Administração e Finanças Públicas Trabalho de Conclusão de Curso – TCC Carga Horária Total
| 40 h 40 h 40 h 60 h 60 h 60 h 60 h 60 h 60 h 60 h 40 h 700 h
|
Avaliações
Não há avaliações ainda.